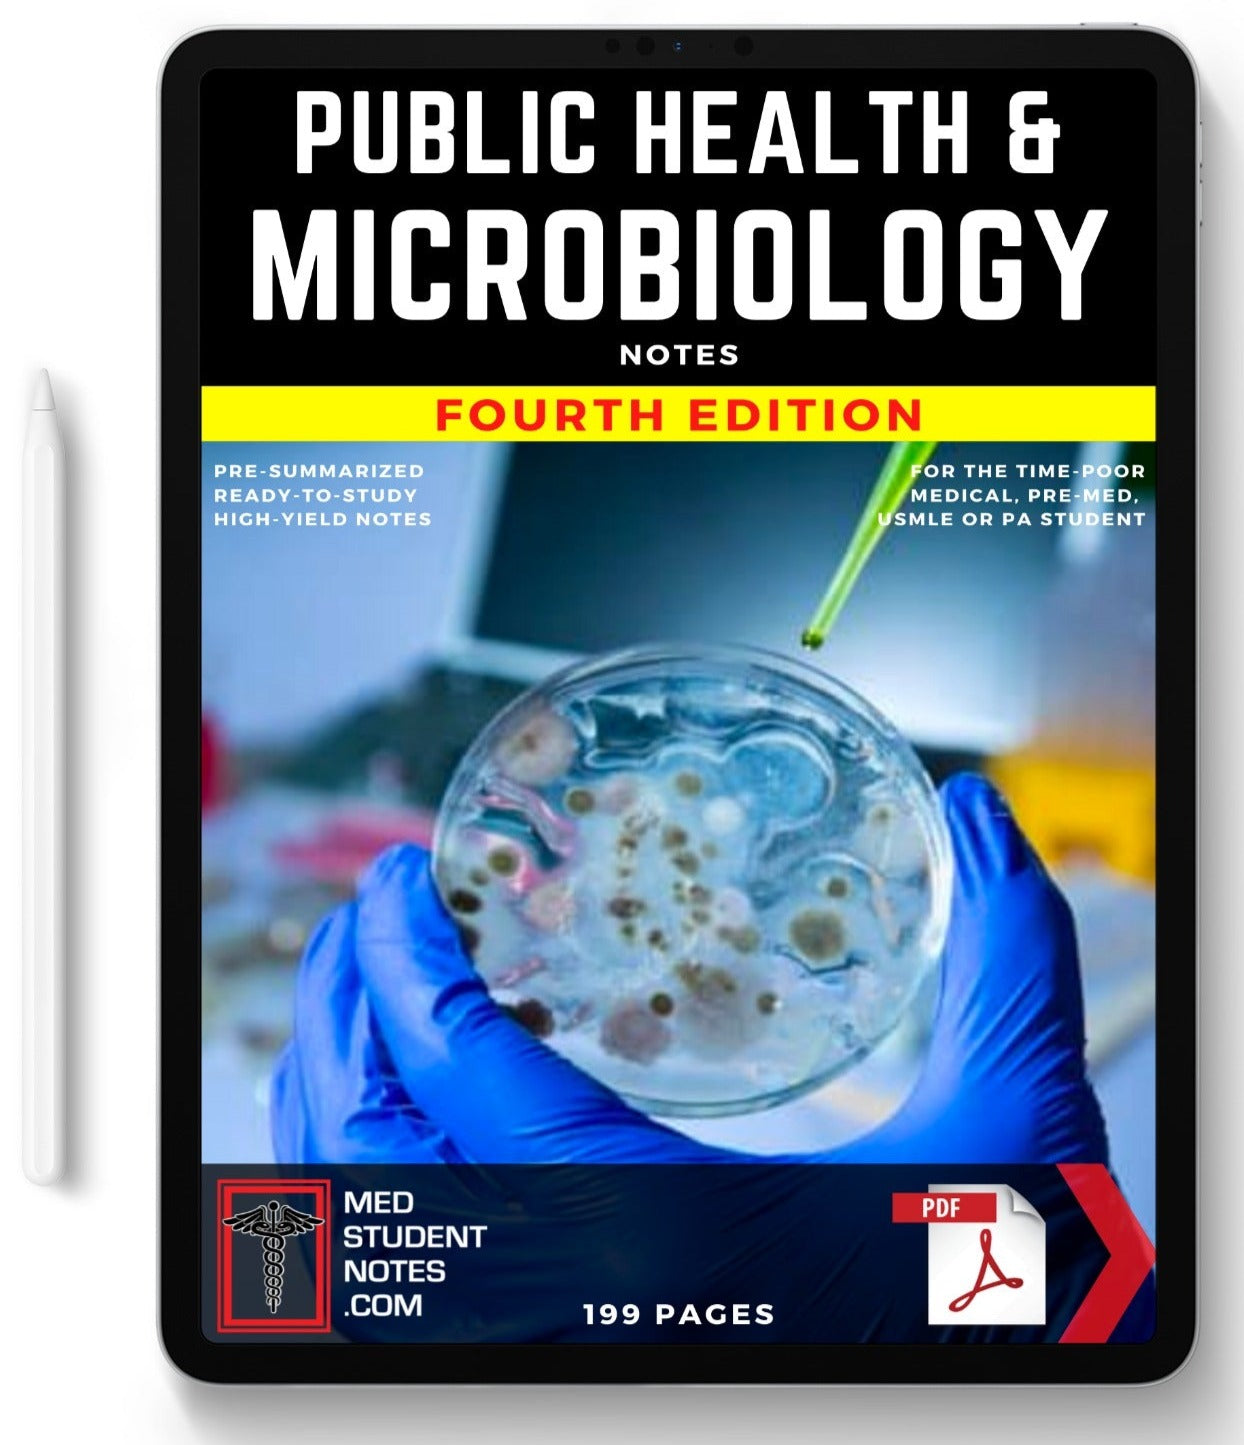

Public Health & Microbiology
OR GET 80% OFF THIS SUBJECT IN THE BUNDLE DEAL HERE!
PUBLIC HEALTH & MICROBIOLOGY
(DELIVERED INSTANTLY TO YOUR INBOX IN PDF FORMAT)
What’s included: Ready-To-Study Summaries of Population Health and Infectious Diseases (Microbiology).
Features:
- Succinct & Richly illustrated
- Downloadable & Printable PDF documents.
- Compatible with OneNote, Notability & Goodnotes.
Content Volume: 199 pages
Contents:
- PUBLIC HEALTH OVERVIEW
- MEASURING HEALTH CONCEPTS
- HEALTH BEHAVIOUR
- CHANGING BEHAVIOUR
- CHRONIC DISEASE & RISK FACTORS
- PANDEMICS
- VACCINATION/IMMUNIZATION
- BASIC CONCEPTS OF INFECTIOUS DISEASES
- MICROBIOLOGY: PRIONS
- MICROBIOLOGY: VIRUSES
- MICROBIOLOGY: PARASITES
- MICROBIOLOGY: BACTERIA
- NOTABLE INFECTIVE DISEASES
- INFECTIVE ENDOCARDITIS
- LYMPHANGITIS
- MYOCARDITIS – VIRAL & TOXIC
- PERICARDITIS
- IMPETIGO (SCHOOL SORES)
- ERYSIPELAS
- CELLULITIS
- SCABIES
- LICE (PEDICULOSIS)
- HERPES SIMPLEX
- CHICKEN POX (VARICELLA ZOSTER)
- HERPES ZOSTER (SHINGLES)
- MEASLES VIRUS
- RUBELLA VIRUS (“GERMAN MEASLES)
- HUMAN PARVOVIRUS B19 (“5TH DISEASE”)
- SCARLET FEVER
- DERMATOPHYTOSIS - “RINGWORM”/“TINEA”
- PARASITIC GUT INFECTIONS
- POLIOMYELITIS
- MENINGITIS
- ENCEPHALITIS
- COMMON COLD (ACUTE RHINITIS)
- PHARYNGITIS (SORE THROAT)
- ACUTE LARYNGOTRACHEOBRONCHITIS (CROUP)
- ACUTE EPIGLOTTITIS
- PERTUSSIS - WHOOPING COUGH
- Q-FEVER
- LEPTOSPIROSIS
- MELIOIDOSIS
- PNEUMONIAS (“Infections of the Lung”)
- BRONCHIOLITIS
- SEASONAL FLU (INFLUENZA A & B)
- BIRD FLU (H5N1)
- SWINE FLU (H1N1)
- SARS & COVID – SEVERE ACUTE RESPIRATORY SYNDROME
- GENITAL HERPES SIMPLEX
- HUMAN PAPILLOMA VIRUS
- SYPHILIS
- CHLAMYDIA
- GONORRHOEA
- DONOVANOSIS
- HEPATITIS C
- HUMAN IMMUNODEFICIENCY VIRUS
- TRACHOMA
- PULMONARY TUBERCULOSIS
- INTESTINAL TUBERCULOSIS
- LEPROSY
- WHIPPLES DISEASE
- METAZOAN PARASITES
- LYMPHATIC FILARIASIS
- MALARIA
- LEISHMANIASIS
- ARBOVIRUSES
- ROSS RIVER VIRUS (RRV)
- DENGUE VIRUS
- YELLOW FEVER
- MURRAY VALLEY ENCEPHALITIS
...OR Get OUR 80% OFF VALUE BUNDLE HERE!
Need to see samples before you buy?... Click here.
Public Health & Microbiology
Sale price$10.47 AUD

